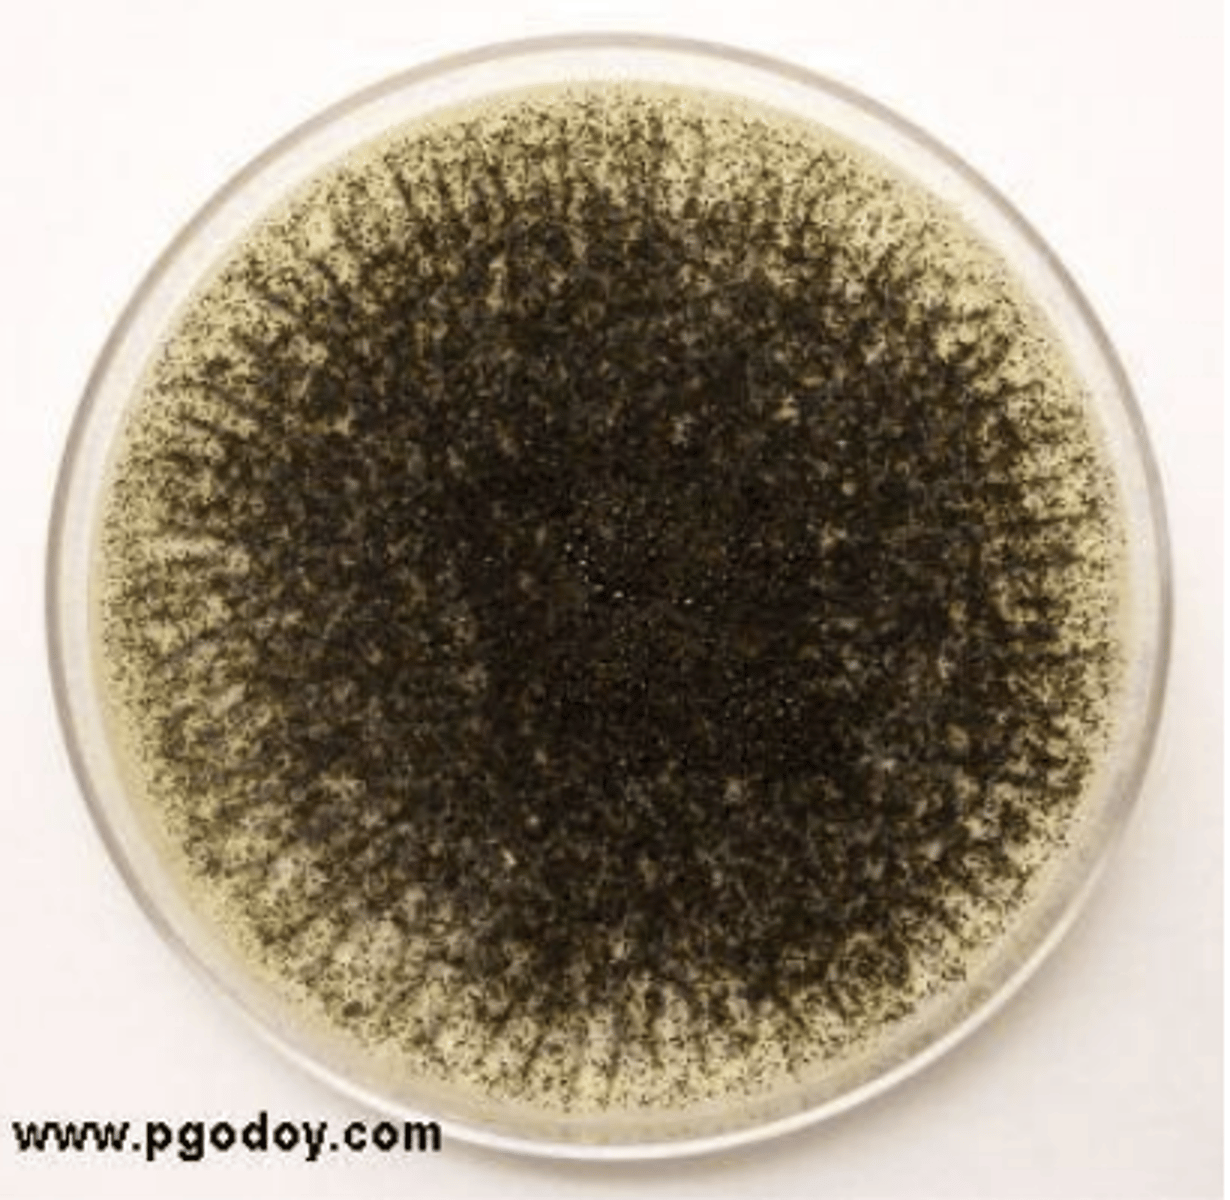
<p>Aspergillus mycelium</p>
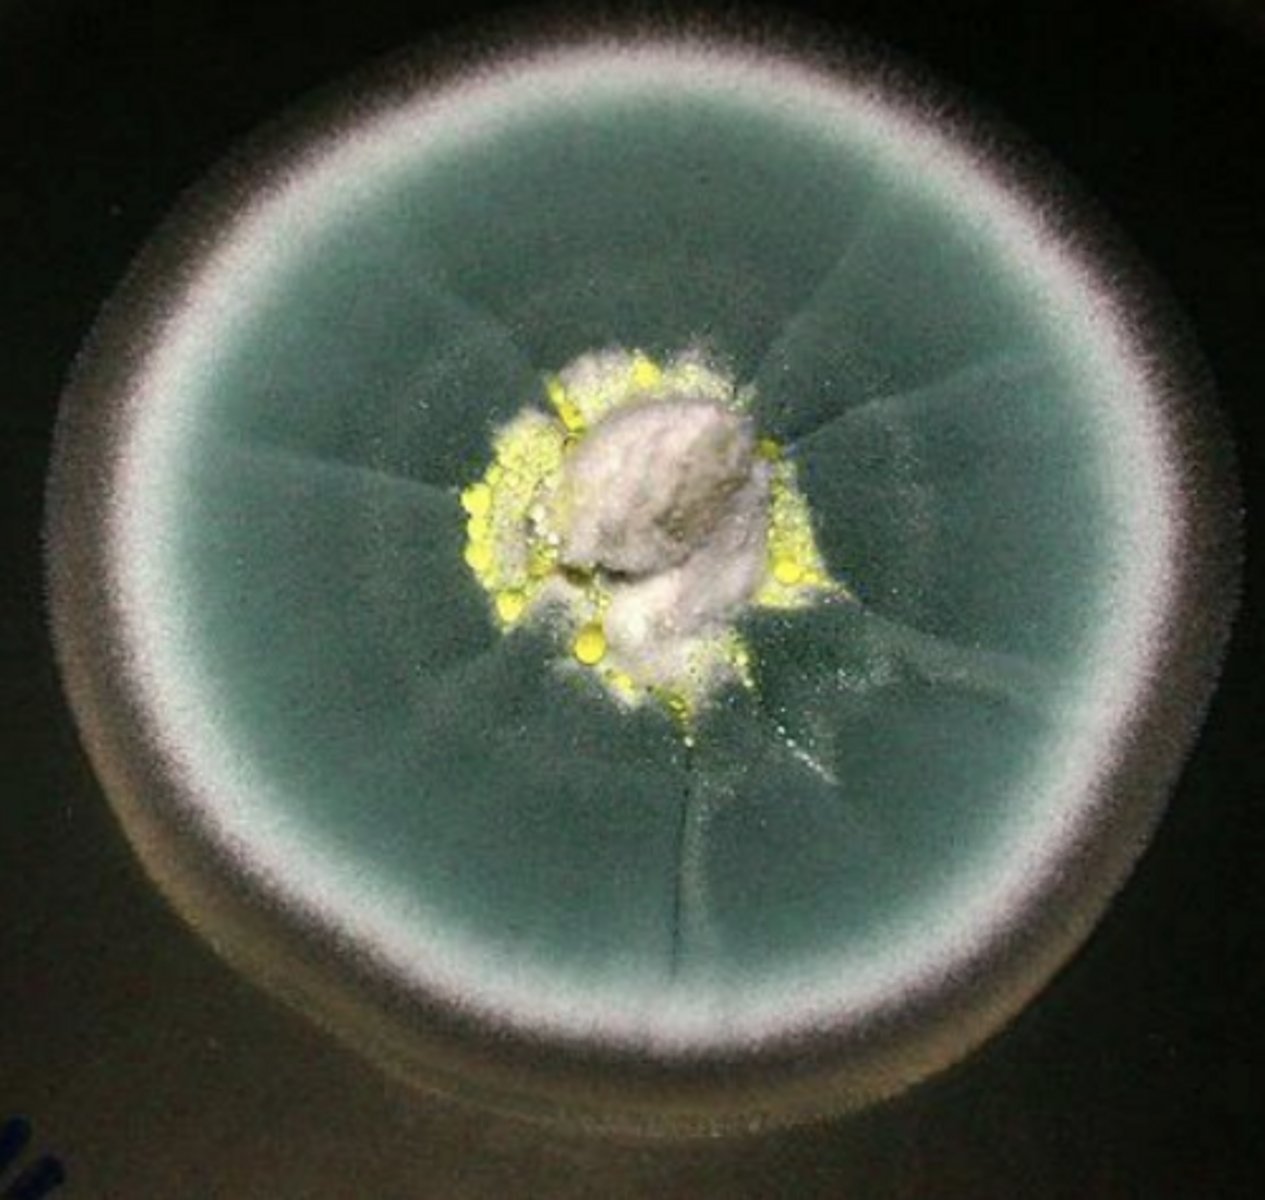
<p>penicillium mycelium</p>
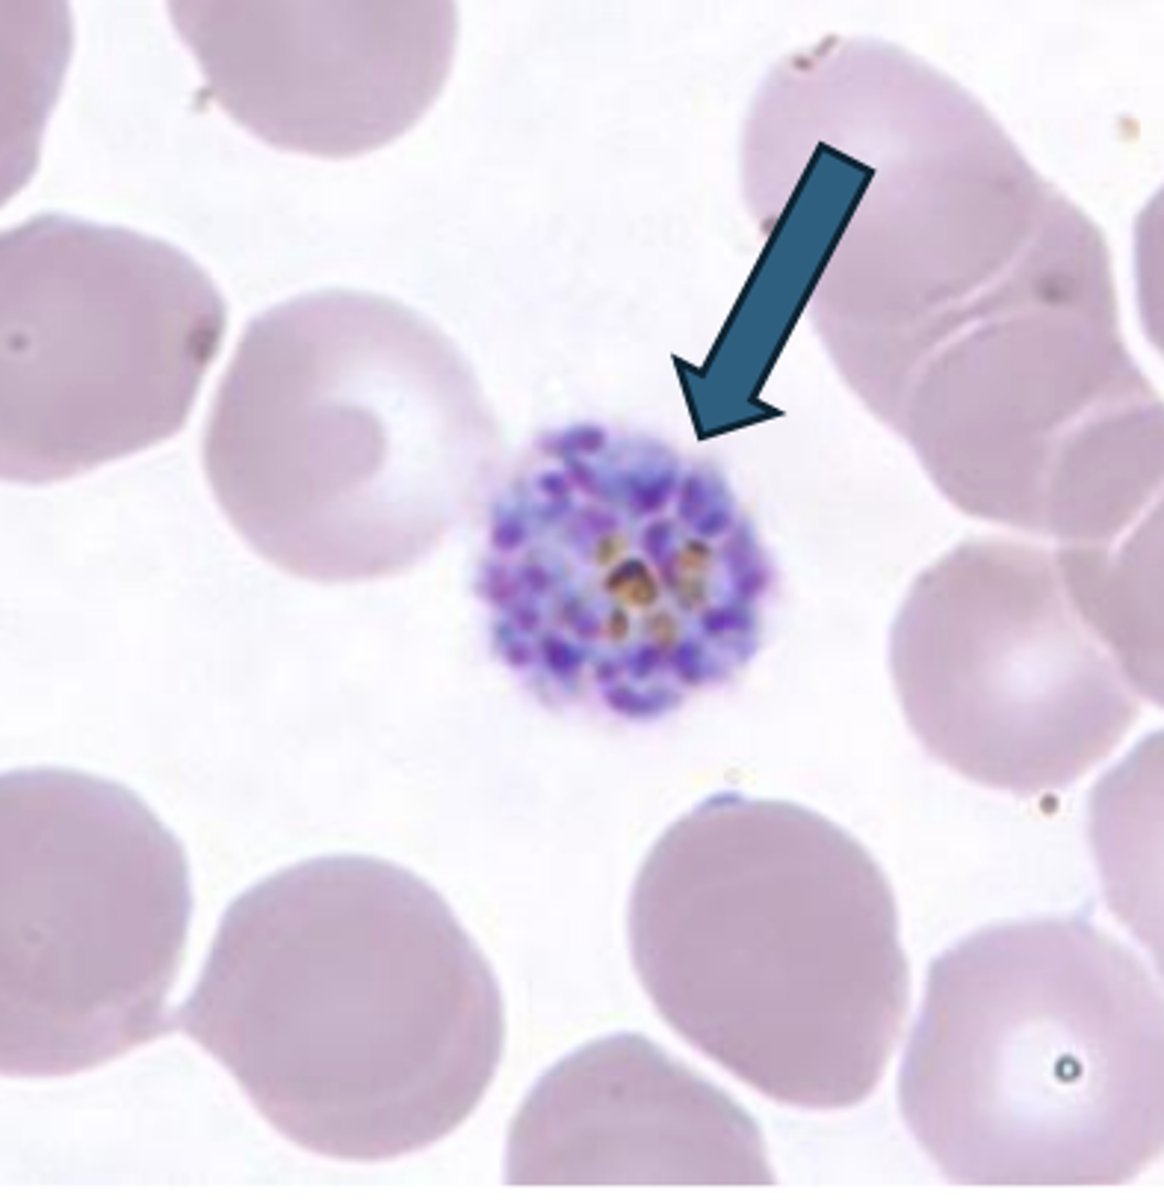
<p>Plasmodium</p>

2nd lab exam
1/51
There's no tags or description
Looks like no tags are added yet.
Name | Mastery | Learn | Test | Matching | Spaced | Call with Kai |
|---|
No analytics yet
Send a link to your students to track their progress
52 Terms
What is the function of the Primary stain, Mordant, Decolorizers, and Counterstains
used in the various differential stains.
What was the function of tetrazolium in the culture medium? How did it help you determine if cells were motile?
to make interpretation easier, it is motile when red is seen radiating outward from stab line
Be able to identify photomicrographs of cells with amphitrichous or peritrichous flagella arrangements
amphitrichous

Be able to identify photomicrographs of cells with amphitrichous or peritrichous flagella arrangements
petritrichous
How does the KOH test work?
gram positive has a thick peptidoglycan layer resisting; gram negative has thin layer that breaks apart
Can you explain why the KOH test produces a "snotty" liquid when Gram negative cells are placed into it and stirred?
they are being lysed due to the release of chromosomal DNA
Know the function of the reagents used in Gram Stain
(CV, I, acetone/alcohol, safranin)
initial stain, helps trap purple in cells, removes dye from peptidoglycan layer, stains colorless cells
what color are negative cells in Gram testing?
red/pink
what color are positive cells in Gram testing?
purple
what reagents are used in Gram staining
crystal violet, iodine, alcohol, safranin
Describe the function of the Congo red (negative)
stains background red, doesn't penetrate capsule
Describe the function of the Maneval's stain
stains cell body purple
Why are capsule stain cells treated differently when the smear is made – no water or heat fixing? (Capsule stain)
heat can cause cells to distort and water will rinse off cells from slide
Identify the staining reagents used in acid fast staining?
carbol fuchsin, methylene blue, decolorizer
what are the functions of reagents used in acid fast staining?
carbol fuchsin
methylene blue
decolorizer
stains cells and penetrates waxy mycolic walls (acid fast cells retain this color)
removes stain from non acid fast cells
stains non acid fast cells
What is different about acid-fast cells compared to non-acid fast cells?
acid fast cells have a waxy mycolic acid cell wall that resists colorization while non acid fast cells do not
Explain how a plaque is formed in a lawn of host cells
occurs when contiguous cells have been lysed by the virus
What is the difference between the proglottid and the scolex segments on tapeworms?
proglottid: adult body divided into segments and carried both egg and sperm
Scolex: the head that is modified with suckers, hooks used for attachment to the intestinal wall
How can bacteriophages be used to treat a disease in people that is caused by bacteria?
they infect, replicate, and lyse harmful bacteria without damaging human cells
Where do restriction enzymes come from and how do they cut DNA?
bacteria; they recognize specific specific DNA sequences and cuts DNA at those sites
What was the function of the Agarose used with the gel?
a filter that separates DNA fragments by size
What was the function of the electrophoresis buffer solution (TAE) used with the gel?
carries electrical current and keeps pH stable so DNA moves correctly
Why do smaller DNA fragments move quicker through Agarose gels?
they pass through gel pores easily
Why use heat with certain stains and not with other ones?
To help certain stains penetrate tough cell structures
How does CHROMAgar™ distinguish between the different Candida species - how is it selective and differential?
Selective: has contents to stop bacterial growth allowing fungi to grow
Differential: contains substrates that react with specific enzymes. Different speices produce different colors
identify this worm
Schistosoma male - Trematoda

identify this worm
Taenia (tapeworm) - cestode

identify this worm
Clonorchis (human liver fluke) - Trematoda

identify this worm
Fasciola (sheep fluke) - Trematoda

identify this worm
Schistosoma female - Trematoda

identify this worm
Enterobius (pinworm) - nematode

identify this worm
necator (hookworm) - nematode

identify this worm
trichinella - nematode

identify this worm
Trichinella (encysted larvae in muscle) - nematode

identify this worm
Ascaris - nematode

identify this spore
Aspergillus mycelium
identify this spore structure (Aspergillus)
condida - asexual

identify this fungus
corpinus

identify this fungus
penicillium mycelium
identify the spore structure
produces conidia; asexual

identify the spore structure
basidiospore; sexual

identify this spore structure; which is sexual, asexual?
Rhizopus - (L) asexual (R) sexual

identify this fungus
Saccharomyces

identify this spore structure
Sordaria; sexual
identify genus name and type
Balantidium coli - trophozoite

identify genus name and type
Entamoeba histolytica - (L) cyst (R) trophozoite

identify genus name and type
Giardia lamblia - (L) cyst (R) trophozoite

identify genus name
Plasmodium
identify genus name
Trypanosoma

identify genus name and type
Trichomonas vaginalis - trophozoite

How did you "enrich" for spore forming bacteria from your soil sample during the Microbe Hunt experiment?
1. Took your soil sample.
2. Suspended it in broth or water.
3. Heated the sample
4. Then plated it on agar
Identify which stain reagents are used (malachite green and safranin). What is the decolorizer?
Malachite green: primary stain
Safranin: counterstain
Decolorizer: water